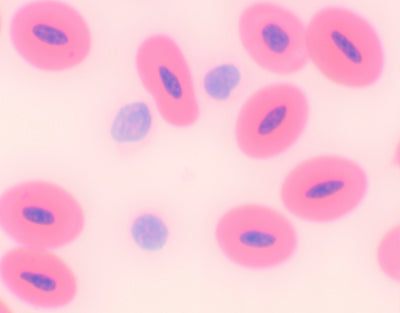
Extensão de sangue de cobra

Se não houver stock disponível, geralmente é entregue em 2/3 semanas.
Pairs well with
Gráfico de tamanho
Na Noveduc disponibilizamos uma vasta gama de catálogos técnicos e científicos, pensados para apoiar escolas, centros de formação e instituições de ensino superior. Aqui encontras soluções completas nas áreas de:
-
Pierron – Física, Química e Biologia
-
Alecop – Equipamento Técnico e Formação Profissional
-
Festo – Automação, Pneumática e Hidráulica
-
CMA – Sensores e Dataloggers para aquisição e análise de dados
Cada catálogo reúne equipamentos de qualidade reconhecida internacionalmente, preparados para responder às exigências dos programas curriculares e da formação profissional moderna.





